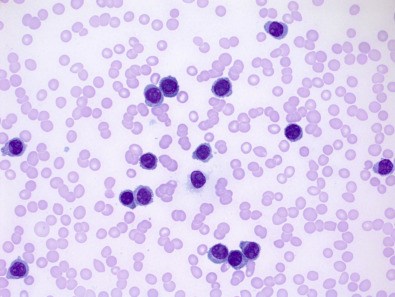

Μια μελέτη που δημοσιεύθηκε στο περιοδικό Nature, έδειξε ότι η λοίμωξη με τον ιό SARS-CoV-2 οδήγησε στην ανάπτυξη ειδικών κυττάρων μνήμης, και πιο συγκεκριμένα πλασματοκυττάρων (είναι τα κύτταρα που παράγουν αντισώματα) μακράς επιβίωσης, στον μυελό των οστών ασθενών που ανέρρωσαν, αν και οι περισσότεροι είχαν εμφανίσει ήπια νόσο. Οι Καθηγητές της Ιατρικής Σχολής του Εθνικού και Καποδιστριακού Πανεπιστημίου Αθηνών, Ευστάθιος Καστρίτης, Γκίκας Μαγιορκίνης , Ευάγγελος Τέρπος και Θάνος Δημόπουλος (Πρύτανης ΕΚΠΑ), συνοψίζουν τα κύρια ευρήματα αυτής της μελέτης.
Τα πλασματοκύτταρα αυτά ήταν ειδικά για αντιγόνα του ιού. Τα πλασματοκύτταρα μακράς επιβίωσης του μυελού των οστών είναι μια βασική και διαρκής πηγή παραγωγής προστατευτικών αντισωμάτων. Έχει αναφερθεί ότι τα αντισώματα κατά του SARS-CoV-2 εμφανίζουν ταχεία πτώση των επιπέδων τους, τους πρώτους μήνες μετά τη μόλυνση, γεννώντας ανησυχίες ότι ενδέχεται να μην αναπτύσσονται στο μυελό πλασματοκύτταρα μακράς επιβίωσης και ότι η χυμική ανοσία έναντι του ιού μπορεί να είναι βραχύβια. Έτσι , οι ερευνητές από την Ιατρική Σχολή του Πανεπιστημίου της Ουάσιγκτον, στο St. Louis, Missouri επιδίωξαν να προσδιορίσουν αν τα κύτταρα αυτά θα ήταν ανιχνεύσιμα σε ασθενείς που ανέρρωσαν μετά από λοίμωξη με COVID, περίπου 7 μήνες μετά την αρχική μόλυνση.
Για τη μελέτη αυτή, οι ερευνητές συνέλεξαν δείγματα αίματος από 77 ασθενείς που ανέρρωσαν μετά από λοίμωξη με τον SARS-CoV-2 περίπου 1 μήνα μετά την έναρξη των συμπτωμάτων, με την πλειονότητα (92,2%) τους να είχαν εμφανίσει ήπια νόσο. Κατόπιν, για την παρακολούθηση, συνέλλεξαν δείγματα αίματος τρεις φορές σε διαστήματα περίπου 3 μηνών.
Η ανάλυση των επιπέδων των κυκλοφορούντων αντισωμάτων έναντι του SARS-CoV-2 στον ορό του αίματος έδειξε ότι οι συνολικοί τίτλοι αντισωμάτων τύπου IgG έναντι της ακίδας του ιού των αναρρωσάντων ασθενών μειώθηκαν ταχέως μεταξύ του 1ου και 4ου μήνα μετά την έναρξη των συμπτωμάτων, με τον μέσο τίτλο να μειώνεται από 6.3 σε 5.7 (μέση διαφορά 0,59 ± 0,06, P <0,001). Ωστόσο, στο διάστημα μεταξύ 4 και 11 μηνών μετά την έναρξη των συμπτωμάτων, ο ρυθμός ελάττωσης επιβραδύνθηκε, οπότε οι μέσοι τίτλοι μειώθηκαν από 5.7 σε 5.3 (μέση διαφορά 0,44 ± 0,10, Ρ <0,001).
Κατόπιν, οι ερευνητές εξέτασαν υλικό μυελού των οστών που λήφθηκε από 18 από τα 77 άτομα, περίπου 7 έως 8 μήνες μετά την αρχική λοίμωξη και από 11 υγιείς εθελοντές χωρίς ιστορικό λοίμωξης ή εμβολιασμού για SARS-CoV-2. Επιπλέον, εξέτασαν διαδοχικά και υλικό μυελού των οστών που συλλέχθηκε από 5 από τα 18 άτομα και 1 επιπλέον δείγμα από αναρρώσαντα δότη περίπου 11 μήνες μετά την αρχική μόλυνση.
Διαπίστωσαν την παρουσία στον μυελό ειδικών πλασματοκυττάρων μακράς επιβίωσης έναντι του αντιγόνου της ακίδας του ιού, 15 IgG και 9 IgA αντίστοιχα, στους 19 ασθενείς που ανάρρωσαν, αλλά σε κανέναν από τους 11 υγιείς μάρτυρες. Επιπλέον, τα πλασματοκύτταρα του μυελού τάξης IgG έναντι της ακίδας του ιού παρέμειναν σε σταθερά επίπεδα στα 5 άτομα από τα οποία λήφθηκαν δείγματα μυελού και στους 11 μήνες μετά τη μόλυνση. Τα πλασματοκύτταρα του μυελού τάξης IgA έναντι της ακίδας βρέθηκαν στα ίδια επίπεδα σε 4 από τα 5 άτομα (σε ένα μειώθηκε κάτω από το όριο ανίχνευσης). Ανάλογα προς τα σταθερά επίπεδα των πλασματοκυττάρων του μυελού, οι ερευνητές παρατήρησαν ότι και οι τίτλοι των αντισωμάτων τάξης IgG έναντι της ακίδας σε αυτούς τους 5 συμμετέχοντες παρέμειναν σταθεροί μεταξύ 7 και 11 μηνών από την έναρξη των συμπτωμάτων. Εν τω μεταξύ, οι τίτλοι IgG έναντι της περιοχής δέσμευσης του υποδοχέα της ακίδας, που ανιχνεύθηκαν σε 4 από τους 5 ασθενείς που ανάρρωσαν, παρέμειναν επίσης σταθεροί μεταξύ 7 και 11 μηνών από την έναρξη των συμπτωμάτων. Επίσης οι ερευνητές διαπίστωσαν ότι κυκλοφορούνα Β-κύτταρα μνήμης που δεσμεύουν την ακίδα του ιού εντοπίστηκαν σε αναρρώσαντες ασθενείς στο πρώτο δείγμα που συλλέχθηκε περίπου ένα μήνα μετά την έναρξη των συμπτωμάτων και διατηρήθηκαν για τουλάχιστον 7 μήνες μετά την έναρξη των συμπτωμάτων.
Η μελέτη αυτή παρέχει τις πρώτες άμεσες ενδείξεις για την παραγωγή ειδικών πλασματοκυττάρων στον μυελό των οστών έναντι ενός αντιγόνου μετά από μια ιογενή λοίμωξη στον άνθρωπο. Συνολικά, τα δεδομένα αυτά παρέχουν ισχυρές ενδείξεις ότι η λοίμωξη με τον SARS-CoV-2 στους ανθρώπους ενεργοποιεί τους δύο βραχίονες της χυμικής ανοσολογική μνήμης: τα μακράς επιβίωσης πλασματοκύτταρα στον μυελό των οστών και τα κυκλοφορούντα Β-κύτταρα μνήμης. Αυτά τα ευρήματα παρέχουν ένα σημείο αναφοράς για την ανοσογονικότητα των εμβολίων έναντι του SARS-CoV-2 και ένα θεμέλιο για την αξιολόγηση της διάρκειας των πρωτογενών χυμικών ανοσολογικών αποκρίσεων που προκαλούνται μετά από ιογενείς λοιμώξεις σε ανθρώπους. Ωστόσο, οι συγγραφείς επεσήμαναν ότι ενώ τα δεδομένα τεκμηριώνουν μια ισχυρή επαγωγή των μακράς επιβίωσης πλασματοκυττάρων στον μυελό των οστών μετά τη μόλυνση από SARS-CoV-2, είναι σημαντικό να σημειωθεί ότι οι ασθενείς της μελέτης εμφάνισαν ως επί το πλείστον ήπια λοίμωξη.
Τα δεδομένα αυτά είναι σύμφωνα με μια άλλη αναφορά που δείχνει ότι τα άτομα που ανέρρωσαν γρήγορα μετά από μια συμπτωματική λοίμωξη με τον SARS-CoV-2 εμφάνισαν μια ισχυρή χυμική ανοσολογική απόκριση. Επομένως, είναι πιθανό ότι οι πιο σοβαρές περιπτώσεις λοίμωξης με τον SARS-CoV-2 θα μπορούσαν να οδηγήσουν σε διαφορετικό αποτέλεσμα σε σχέση με τα μακράς επιβίωσης πλασματοκυττάρα στον μυελό λόγω απορρυθμισμένων χυμικών ανοσολογικών αποκρίσεων.
Η μακράς διάρκειας ανοσία που περιγράφουν οι ερευνητές φαίνεται ότι ενισχύεται και από τα πρώιμα αποτελέσματα που αφορούν την T-κυτταρική ανοσία που έχουν περιγραφεί σε μία μελέτη προδημοσιευμένη από τον Δεκέμβριο του 2020.
(https://www.biorxiv.org/content/10.1101/2020.12.08.416636v1.full.pdf
Πιο συγκεκριμένα οι ασθενείς που είχαν αναρρώσει έδειξαν παρατεταμένη πολυλειτουργική μνήμη έναντι αντιγόνων του SARS-CoV-2 η οποία σε περίπτωση επαναλοίμωξης θα μπορούσε να οδηγήσει σε ταχεία ανάκληση της ανοσολογικής απόκρισης. Οι ερευνητές είχαν επίσης παρατηρήσει ότι οι ασθενείς που ανέρρωσαν είχαν παρατεταμένες ανοσολογικές αλλαγές στου σχετικούς αριθμούς των T-κυττάρων (CD4, CD8), την έκφραση δεικτών ενεργοποίησης/εξουθένωσης, και στην κυτταρική διαίρεση. Η αλληλεπίδραση της κυτταρικής με τη χυμική ανοσίαλ καθώς,και η προστασία που προσφέρει ο συνδυασμός σε πιθανότητα επαναλοίμωξης από τον ιό SARS-CoV-2 δεν είναι πλήρως κατανοητά. Σε κάθε περίπτωση η διαλεύκανση του μηχανισμού της μακράς ανοσίας θα βοηθήσει να σχεδιάσουμε χρονικά καλύτερα τον εμβολιαστικό προγραμματισμό.